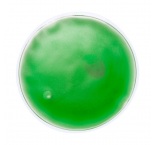

Transparentné tepelný, opakované použiteľný, vankúšik s farebným gélom.
Materiál:
plast
Rozmery:
?100×10 mm
Skladom:
Na dopyt
U dodávateľa:
40 014 ks
Dodanie:
2-3 pracovné dni
Kategórie:
Osobné a cestovné potreby
,
Ohrievacie vankúšiky
0,86 €